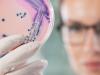
Lucruri neasteptate care au mai multi microbi decat ati crede

bacilul auriu

Tipuri de pneumonie: simptome, cauze, tratament
Dr. Antonius Adriana
Medic specialist Medicina Interna
Generalitati Pneumonia este o boala grava, care continua sa faca victime peste tot in lume. Anual, ea afecteaza aproximativ 450 de milioane de persoane, reprezentand 7% din populatia globului si provoaca 4 milioane de decese. In tarile sarace sau in curs de dezvoltare, ea ramane prima cauza de mortalitate in randul copiilor. Simptomele pneumoniei Pneumonia este o inflamatie a plamanilor, cauzata cel mai adesea de o infectie cu bacterii sau virusuri. Boala este cu atat mai periculoasa cu cat sistemul imunitar este mai slabit. In rare cazuri, pneumonia este data de o infectie micotica (cu fungi ori ciuperci) sau parazitara. Cele mai frecvente simptome includ: - tuse productiva (intalnita cu o frecventa de 79%-91%); - oboseala (frecventa de 90%); - febra insotita de frisoane (frecventa de 71–75%); - respiratie grea, cu modificari de ritm (dispnee - frecventa de 67–75%); - sputa (frecventa de 60–65%); - durere in piept, ascutita sau sub forma de junghiuri, in timpul... [continuare]

Care sunt cauzele infectiilor urinare frecvente?
Dr. Ileana Nasui
Medic Rezident - Medicina Interna
Generalitati Tractul urinar este format din rinichi, uretere, vezica urinara si uretra. Infectia urinara este provocata de agenti patogeni precum bacterii, paraziti si fungi, care de regula se localizeaza in tractul urinar. Uretrita reprezinta o infectie uretrala, cistita inseamna o infectie a vezicii urinare, iar in cazul in care pacientul este diagnosticat cu pielonefrita, atunci infectia este localizata la rinichi. Cistita, cum este numita in popor infectia urinara, are ca principale simptome urinarile frecvente insotite de usturime si durere la urinare. Afectiunea este mai des intalnita la femei decat la barbati. Cauzele infectiilor urinare recurente Factorii determinanti ai infectiei urinare sunt reprezentati de enterobacterii (Escherichia Coli, Klebsiella, Proteus) si, mai rar, de virusuri sau fungi. Cu toate acestea, exista si anumite ciuperci care pot infecta tractul urinar, cauzand astfel aparitia vaginitei. Candida este organismul cel mai susceptibil de a provoca... [continuare]

Enterocolita acuta – semnele care trebuie sa te trimita la medic!
Dr. Antonius Adriana
Medic specialist Medicina Interna
Ce este enterocolita acuta? Enterocolita acuta este o inflamatie a mucoasei intestinului subtire si a colonului, determinata de diverse infectii cu bacterii, virusuri, ciuperci si paraziti. Este o afectiune destul de des intalnita in randul adultilor, dar si a copiilor, preponderent intalnita mai frecvent in sezonul cald. Transmiterea enterocolitei acute se face pe cale digestiva prin contact direct sau prin obiecte contaminate. Mai exact, enterocolita acuta se transmite prin consumul apei nepotabile, a carnii insuficient preparate termic, a lactatelor nepasteurizate, a fructelor si legumelor nespalate, la cultivarea carora au fost folosite ingrasaminte naturale, dar si prin ingestia de alimente sau lichide contaminate cu fecale de la o persoana la alta, mai ales in situatiile in care cand nu sunt respectate normele elementare de igiena. Simptomele enterocolitei acute Enterocolita debuteaza brusc si se manifesta prin scaderea apetitului si stari de greata. Crampele... [continuare]
Lucruri neasteptate care au mai multi microbi decat ati crede
Autor: SfatulMedicului
Generalitati Multe obiecte pe care avem obiceiul de a le utiliza zilnic, fie din necesitate, fie din placere, contin foarte multi microbi si bacterii care ne pot imbolnavi. Principalele lucruri contaminate • Unele studii au demonstrat ca tastatura unui computer sau a unui laptop poate fi adeseori mult mai murdara si mai plina de microbi decat vasul de toaleta. Este indicat ca aceste obiecte sa fie sterse o data pe zi cu un servetel umezit in solutie antibacteriana, dezinfectant sau alcool sanitar. • Telefonul mobil este si el o sursa de infectie. Se pare ca acesta are de peste zece ori mai multi microbi decat scaunul de toaleta, sustin anumiti cercetatori. De aceea, zilnic ar trebui curatat si sters cu solutii dezinfectante, deoarece riscul de imbolnavire este mare. Telefoanele mobile contin peste o mie de bacterii, printre care salmonella, stafilococul auriu, cat si E. coli. Totodata, dupa ce ati folosit [continuare]

Generalitati Uretrita reprezinta o infectie a uretrei, canalul care face legatura intre vezica urinara si exterior si foloseste la eliminarea urinii. Cel mai frecvent, infectia este cauzata de bacterii, contactate, de obicei, prin boli cu transmitere sexuala. Sunt de asemenea frecvente infectiile determinate de virusuri. Flora microbiana a uretrei normale Uretra normala contine in secretiile sale fiziologice o flora microbiana proprie, care nu produce nici o tulburare persoanei respective si a carei prezenta nu se manifesta clinic. Aceasta flora constituie ceea ce se numeste eubacteria uretrala. Alti autori considera uretra ca fiind sterila in totalitate sau partial. Cercetarile clinice si experimentale au aratat ca uretra contine microbi. Din cercetarile mai vechi in domeniu reiese ca uretra normala contine multiple specii de germeni (peste 20 de specii) dintre care stafilococi, streptococi, colibacili, piocianic, enterococi, sarcine, tetrageni, levuri etc. Cercetari mai... [continuare]

Locuri comune in care se gasesc cei mai multi microbi
Autor: SfatulMedicului
Generalitati Clantele, telefonul sau tastatura calculatorului si chiar buretele de vase sunt mai murdare pana si decat colacul vasului de toaleta, cel pe care toata lumea s-a obisnuit sa il considere ca fiind purtatorul celor mai multi microbi. Practic, microbi sunt peste tot, insa anumite zone ale casei sau ale locurilor care ne inconjoara devin prielnice pentru inmultirea acestor microorganisme. Microbii sunt peste tot: in aer, in apa, in sol, dar si pe suprafetele comune, cele care vin in contact cu multe persoane, fiind practic cele mai expuse acumularii de microbi. Locuri propice de dezvoltare a microbilor Tastatura Tastatura adaposteste numerosi microbi, dar si bacterii. Practic, aceste microorganisme sunt transferate pe taste de pe maini si, in asociere cu celulele moarte, cu ramasitele de mancare si de transpiratie ajunse aici, gasesc un mediu propice de inmultire. Cele mai murdare sunt tastaturile din birouri, intrucat ele colecteaza microbii mai multor persoane,... [continuare]

Poate cineva sa ma ajute in interpretarea analizelor? Examen secretie vaginala.Frotiu direct:Absente PMN,frecvente celule epiteliale,rari bacili Gram pozitivi cu capete drepte,moderat frecventi bacili Gram negativi grosi,cu capete rotunjite.Examen bacteriologic -culturi:Escherichia coli.Klebsiella pneumoniae.Examen micologic:Levuri necrescute la 5 zile.Trichomonas :absent.Mentionez ca sant insarcinata in 17 saptamani si sant foarte stersata.Este ceva grav? la doctora mea abia saptamana viitoare am programare,dar pana atunci nu mai am liniste.Va multumesc. [continuare]
Mucoviscidoza
boala ereditara caracterizata printr-o vascozitate anormala a mucusului pe care il secreta glandele intestinale, pancreatice si bronhice. Frecventa si cauza - Mucoviscidioza afecteaza mai ales subiectii albi, printre care ea atinge un copil din 2000 pana la 2500 copii. Este vorba de o boala cu transmisie autosomica (gena purtatoare este situata pe cromozomii nesexuali) recesiva (gena trebuie sa fie primita atat de la mama, cat si de la tata pentru a se dezvolta boala) simptome si semne - Cum secretiile mucoase, prea vascoase, se scurg prost in conducturile naturale, se produc dilatatii chistice, chiar obstructii. Manifestarile pot debuta de la nastere printr-o ocluzie intestinala a nou-nascutului, o intarziere a evacuarii meconiului, un icter (provocat de obstructia cailor biliare) sau o obstructie a bronhiilor mici care poate conduce la o prabusire respiratorie. Dar cele care atrag mai intai atentia la sugar sunt, in general. problemele respiratorii, tuse persistenta,... [continuare]
Fibroza chistica
boala ereditara caracterizata printr-o vascozitate anormala a mucusului pe care il secreta glandele intestinale, pancreatice si bronhice. Frecventa si cauza - Mucoviscidoza afecteaza mai ales subiectii albi, printre care ea atinge un copil din 2000 pana la 2500 copii. Este vorba de o boala cu transmisie autosomica (gena purtatoare este situata pe cromozomii nesexuali) recesiva (gena trebuie sa fie primita atat de la mama, cat si de la tata pentru a se dezvolta boala) simptome si semne - Cum secretiile mucoase, prea vascoase, se scurg prost in conducturile naturale, se produc dilatatii chistice, chiar obstructii. Manifestarile pot debuta de la nastere printr-o ocluzie intestinala a nou-nascutului, o intarziere a evacuarii meconiului, un icter (provocat de obstructia cailor biliare) sau o obstructie a bronhiilor mici care poate conduce la o prabusire respiratorie. Dar cele care atrag mai intai atentia la sugar sunt, in general. problemele respiratorii, tuse persistenta,... [continuare]
Fibroza chistica a pancreasului
boala ereditara caracterizata printr-o vascozitate anormala a mucusului pe care il secreta glandele intestinale, pancreatice si bronhice. Frecventa si cauza - Mucoviscidoza afecteaza mai ales subiectii albi, printre care ea atinge un copil din 2000 pana la 2500 copii. Este vorba de o boala cu transmisie autosomica (gena purtatoare este situata pe cromozomii nesexuali) recesiva (gena trebuie sa fie primita atat de la mama, cat si de la tata pentru a se dezvolta boala) simptome si semne - Cum secretiile mucoase, prea vascoase, se scurg prost in conducturile naturale, se produc dilatatii chistice, chiar obstructii. Manifestarile pot debuta de la nastere printr-o ocluzie intestinala a nou-nascutului, o intarziere a evacuarii meconiului, un icter (provocat de obstructia cailor biliare) sau o obstructie a bronhiilor mici care poate conduce la o prabusire respiratorie. Dar cele care atrag mai intai atentia la sugar sunt, in general. problemele respiratorii, tuse persistenta,... [continuare]
Boala fibrochistica
Boala ereditara caracterizata printr-o vascozitate anormala a mucusului pe care il secreta glandele intestinale, pancreatice si bronhice. Frecventa si cauza - Mucoviscidioza afecteaza mai ales subiectii albi, printre care ea atinge un copil din 2000 pana la 2500 copii. Este vorba de o boala cu transmisie autosomica (gena purtatoare este situata pe cromozomii nesexuali) recesiva (gena trebuie sa fie primita atat de la mama, cat si de la tata pentru a se dezvolta boala) Simptome si semne - Cum secretiile mucoase, prea vascoase, se scurg prost in conducturile naturale, se produc dilatatii chistice, chiar obstructii. Manifestarile pot debuta de la nastere printr-o ocluzie intestinala a nou-nascutului, o intarziere a evacuarii meconiului, un icter (provocat de obstructia cailor biliare) sau o obstructie a bronhiilor mici care poate conduce la o prabusire respiratorie. Dar cele care atrag mai intai atentia la sugar sunt, in general. problemele respiratorii, tuse persistenta,... [continuare]
Sinerdol, capsule
Compozitie O capsula contine 150 mg rifampicina de semisinteza. Actiune terapeutica Sinerdol este un antibiotic de semisinteza cu spectru larg de actiune care cuprinde germeni grampozitivi (pneumococ, stafilococ auriu, streptococ piogen, enterococ, bacil carbunos si difteric, clostridii) si gramnegativi (gonococ, meningococ, Haemophilus, proteus, bacil piocianic, colibacil, salmonelle, shigele s.a.). De cea mai mare importanta insa este actiunea Sinerdolului impotriva bacilului tuberculos. Sinerdol nu are actiune antifungica. Sinerdol actioneaza bactericid fata de germenii aflati in faza de multiplicare (concentratiile minime inhibitorii in aceasta faza sunt aproape de cele bactericide), cei in repaus nefiind aproape deloc influentati. Mecanismul de actiune asupra germenilor microbieni consta in inhibitia specifica a ARN-polimerazei acestora, fara a fi influentata aceea a organismului gazda. Sinerdol se resoarbe bine din tractul digestiv, ajunge in sange in concentratii... [continuare]
Cefoperazona, flacon injectabil
Ce este Cefoperazona si pentru ce se utilizeaza Indicatii Antibiotic din grupul cefalosporinelor cu actiune bactericida prin inhibarea sintezei peretelui celular bacterian. Cefozon este activ invitro impotriva unei varietati largi de germeni patogeni si este rezistent la degradarea de catre betalactamaza. Microorganismele sensibile sunt: Bacterii gram negative: stafilococ auriu cu sau fara penicilinaza, Stafilococcus epidermis, Stafilococcus pyogenes grup A beta-hemolitic, streptococcus agalactiae grup B beta-hemolitic, streptococcus faecalis, majoritatea varietatilor de streptococ beta-hemolitic. Bacterii gram pozitive: E. coli, Klebsiella, Enterobacter, Haemophilusinfluenzae (varietatile betalactamaso pozitive sau negative), Proteus (mirabilis, vulgaris, morgani), Salmonele si Shigelle, Pseudomonas, Neisseria gonoree (betalactamaso pozitiva sau negativa), Neisseria meningitidis, Bordetella pertussis, Yersinia enterocollitica. Germeni anaerobi: coci gram pozitivi si... [continuare]
Nitrofurantoin, comprimate
Indicatii infectii urinare acute - bacteriurie vezicala, pielonefrita, profilaxia de durata a infectiilor urinare recurente (dupa ce urina a fost sterilizata printr-un chimioterapic eficace). Doze si mod de administrare Adulti: in infectiile acute 1/2-1 comprimat (50 sau 100 mg de 4 ori/zi, la mese), 1-2 saptamani; pentru profilaxie 1/2-1 comprimat in fiecare seara, timp indelungat. copii (mai mari de 1 an): 4-5 mg/kg corp si zi in 4 prize, in infectiile acute; 2,5 mg/kg corp si zi in infectiile cronice. Actiune terapeutica Antibacterian cu spectru larg, realizeaza in urina concentratii bacteriostatice sau bactericide pentru mare parte din germenii infectiilor urinare; sunt sensibili majoritatea colibacililor si alti bacili coliformi, parte din tulpinile de Klebsiella-Aerobacter, stafilococul auriu si enterococul; rezistenta se dezvolta rar. Dupa administrarea orala realizeaza concentratii eficace numai in urina. Compozitie Comprimate enterosolubile continand... [continuare]

copilul meu are safilococ are 2 ani si 4 luni. prima data i s-a dat biseptol 10 zile si dupa am facut pauza 20. am refacut analizele si iar i-a iesit dar de data asta e rezistent la biseptol. Medicul de familie a zis ca nu-i dam nimic momentan dar daca raceste sa revin si sa vedem ce facem. intrebarea mea este sa astept sau ce sa fac? [continuare]

Pseudomonas spp si pioceanic
bunaziua asi dorii sa stiu daca virusul pseudomonas spp si pioceanic e acelasi multumesc [continuare]

Am o nelamurire,va rog sfatuiti-ma!!!
Dupa recoltarea exudatului faringian,implicit examinarea microscopica a acestuia se efectueaza frotiuri pentru examenul bacteriologic direct.Ei,nedumerirea mea este:dupa realizarea frotiurilor cum se ajunge la insamantarea pe mediul de cultura?Va rog sa-mi raspundeti,este foarte important in realizarea lucrarii de licenta. [continuare]
- « Pagina precedenta
- Pagina urmatoare »




Urmareste Sfatul Medicului
Aboneaza-te la Newsletter